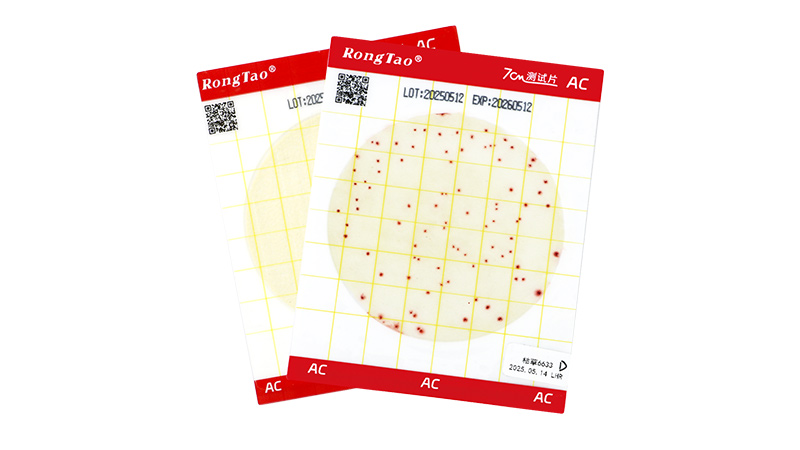
产品一.jpg

作为食品安全技术领域规模最大、人气最旺和最受欢迎的行业盛会之一,CBIFS第十八届食品安全技术论坛暨太平洋食安展将于2026年4月9日-10日在苏州举办。
青岛海博生物确认参展本次论坛,欢迎各位领导专家和客户朋友参观交流、合作洽谈!


青岛高科技工业园海博生物技术有限公司
青岛海博生物成立于2000年,专注于微生物培养基的研发、生产和销售,致力于为客户提供优质的产品和高效的技术服务。目前我们拥有一个干粉生产车间、两个万级洁净生产车间,生产微生物干燥培养基、即用型培养基和配套用的添加剂三大系列,共3000多个品种.
公司目前除了在培养基领域不断深耕和精进,还在构建高效智能化的实验室方面进行探索,相继推出了智能平皿分装仪、重量稀释仪、智能试管分装仪、明胶强度测定仪、凝胶强度测定仪等实验室小型仪器,推进传统实验室转型。除了实验室仪器,依托海博生物基地,全面实现了工业生产设备的生产,如多通道大型平皿生产设备、全自动化的各种瓶装、管装、袋装液体培养基的生产设备等,欢迎有工业生产用设备需求的用户来洽谈合作。
我们以工匠精神不断追求高质量高服务的产品为企业目标,以不断创新保持行业领先水平,并秉承协作、诚信、安全、节约的核心价值观,培养和引进一批优秀的技术和管理人才,保证海博培养基在生产、检验、销售的各环节均符合国家标准、药典标准、ISO、USP、EP等标准。
电话:0532-81935226
地址:青岛市城阳区锦汇路1号A2栋
网址:www.hopebiol.com

- 扫码关注公众号 -
7cm测试片
青岛海博生物7CM测试片采用7CM大直径培养层,菌落分布更均匀,计数准确性媲美国标平板;一次成型的硬质塑料背板设计,平整不易变形,确保培养稳定性;无需压板,加样后覆盖上膜即可,操作一步到位,有效防止菌液外溢,杜绝污染。适用于食品、环境、医疗等领域的快速微生物检测,助力企业高效通过质量认证。精准数据,简化操作——让微生物检测更轻松!
涵盖菌落总数测试片(AC)、大肠菌群测试片(CC)、霉菌/酵母菌测试片(YM)。
是一种用于快速检测样本中微生物含量的即用型检测工具,主要检测菌落总数、大肠菌群、霉菌/酵母菌等指标。

微生物实验室智能设备系列产品
青岛海博·青岛格汇 聚焦微生物实验室智能化升级,精准匹配行业需求,近年来相继推出了智能平皿分装仪、重量稀释仪、智能试管分装仪、明胶强度测定仪、凝胶强度测定仪等实验室小型仪器,助力传统实验室实现高效转型。
依托海博生物实验室的多样化测试与深度试用,每一款产品均历经反复打磨与优化,切实解决实验室操作中的痛点。设备设计贴合实验员使用习惯,并支持个性化定制服务,精准适配您的多样化需求!
适用于微生物实验室小批量试管无菌分装,大批量试剂无菌分装,样品高效稀释,平皿培养基无菌分装,胶体强度测定等多个方面。

微生物培养基系列产品
青岛海博生物自成立以来就专注于微生物培养基的研发和生产,产品品种多达3000多种,是国内微生物产品品种最全的厂家之一。产品涵盖微生物检测实验的各个方面,包括干粉/颗粒培养基,显色培养基,即用型培养基(试管、平板、均质袋,瓶装液体等),生化鉴定系列,采样系列,菌种保存系列,细胞培养基,分子生物学系列等,2025年还新推出定量菌株和涂抹海绵采样系列。除常规产品外,我们还提供专业的培养基定制服务。




